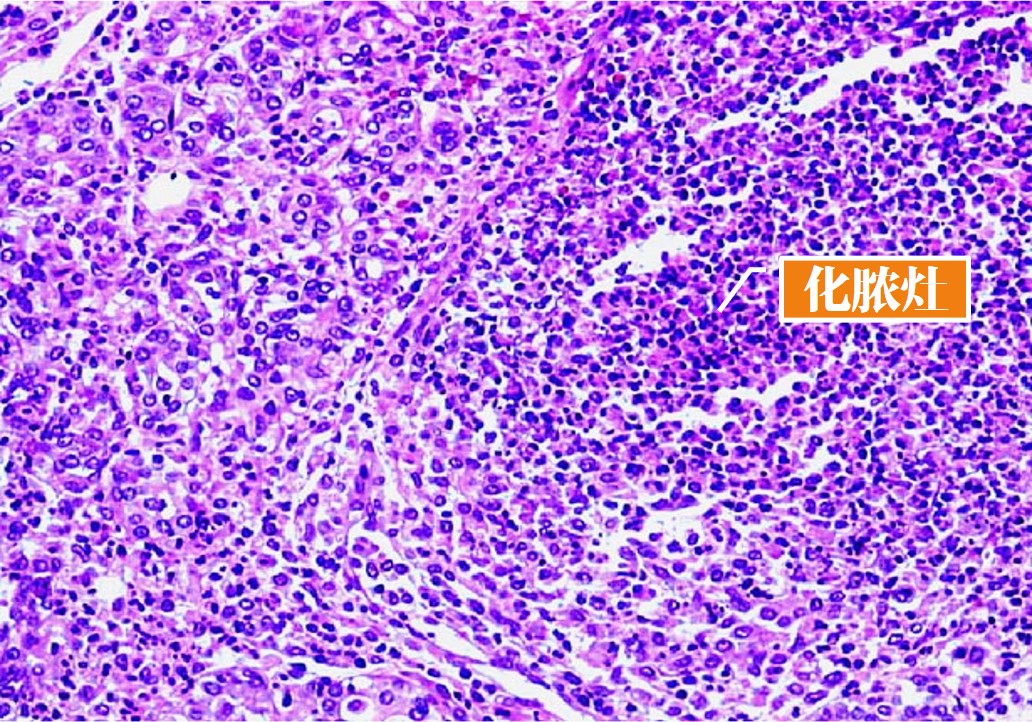
12.1-1 急性唾液腺炎.jpg

-
1 章节要点
-
2 章节测验
第一节 唾液腺非肿瘤性疾病
一、唾液腺炎症
★1)急性唾液腺炎(acute siladentitis)
①病因
致病菌:主要是金黄色葡萄球菌、溶血性链球菌;从导管进入,逆行感染;
诱因:身体衰弱、抵抗力降低;反射性腮腺分泌功能降低;唾液腺导管阻塞。
②临床表现
主要好发腮腺,常单侧受累;老人多见。早期腮腺区疼痛、肿胀,腮腺导管口红肿,并有脓汁自导管口溢出;严重者可形成脓肿,致唾液分泌量减少;炎症可波及皮肤和外耳道;多有发热,血中白细胞增多,唾液涂片可见中性粒细胞和细菌。
③病理改变
腮腺导管扩张,管腔内有大量中性粒细胞聚集;导管周围及腺实质内有大量中性粒细胞浸润;唾液腺组织广泛破坏和坏死,形成化脓灶(图12.1-1)。
图12.1-1 急性唾液腺炎
★2)慢性唾液腺炎(chronic sialadenitis)
①病因
导管阻塞和放射线损伤后继发感染;由急性唾液腺炎转为慢性;长期口腔内压力增高可逆行感染;自身免疫性疾病。
②临床表现
化脓性多见,多发生于下颌下腺及腮腺,常为单侧;
唾液腺局部肿大,酸胀感,进食时加重。挤压患侧唾液腺,导管口流出黏稠而有咸味的液体;
唾液腺造影(图12.1-2):表现为主导管呈腊肠状,末梢导管呈点球状扩张。

图12.1-2 慢性唾液腺炎(造影)
③病理变化
腺泡萎缩、消失而为增生的纤维组织取代;小叶内导管上皮增生,并可见鳞状化生;唾液腺导管扩张,导管内有炎症细胞;导管周围及纤维间质中有淋巴细胞和浆细胞浸润(图12.1-3),或形成淋巴滤泡。

图12.1-3 慢性唾液腺炎(光镜)
3)慢性复发性腮腺炎(chronic recurrent parotitis)
①病因
与自身免疫病有关。
②临床表现
儿童以3~6岁多见,无性别差异;成人以中年女性多见;单侧或双侧腮腺反复肿胀;唾液浑浊黏稠,挤压腺体导管口有脓液或胶冻状液体溢出;儿童青春期后可自愈。
唾液腺造影:末梢导管呈点状或斑片状扩张。
③病理变化
腺泡细胞萎缩;小叶内导管囊状扩张,导管上皮增生;附近导管周围有淋巴细胞浸润或形成淋巴滤泡(图12.1-4)。

图12.1-4 慢性复发性腮腺炎
★4)流行性腮腺炎(epidemic parotitis, mumps)
①病因
副黏液病毒,唾液飞沫传播。
②临床表现
儿童;起病时全身症状;局部症状为腮腺肿胀、疼痛,咀嚼和进食时疼痛加剧,导管口红肿;多为双侧腮腺同时发病。
③病理变化
非化脓性渗出性炎症;
腺泡细胞内含空泡,可见包涵体;导管上皮水肿,管腔充满坏死细胞和渗出物;腺体被膜充血,间质水肿,淋巴、浆细胞和巨噬细胞浸润。
血液和尿中淀粉酶升高,有助于早期诊断或鉴别诊断。
5)巨细胞包涵体病(cytomegalic inclusion disease)
①病因
巨细胞病毒,接触传染。
②临床表现
2岁以下婴儿;主要侵犯腮腺,大多无临床症状,部分患儿有明显的肝脾肿大、血小板减少性紫癜或出血倾向;
如果发生在胎儿期,先天性巨细胞包涵体病,主要表现小颅畸形,伴智力障碍。
③病理变化
导管上皮出现包涵体,包涵体在胞核内,或在胞浆的近管腔侧,为圆形,大多嗜伊红,含包涵体的细胞可发生变性、崩解。腺管周围有淋巴细胞、浆细胞和单核细胞浸润,血管扩张充血(图12.1-5)。

图12.1-5 巨细胞包涵体病
★二、舍格伦综合征(Sjogrensyndrome)
①概念
是一种以慢性唾液腺炎、干燥性角膜炎和口干症为主要临床表现、病因不明的自身免疫性疾病,常合并全身性红斑狼疮与类风湿性关节炎等系统性自身免疫性疾病。。
②临床
多见于40岁以上女性;
主要表现为患者唾液分泌量减少,致严重口渴和龋齿;口腔检查见黏膜干燥,镜面舌;唇、颊、舌黏膜出现裂纹,泪液分泌量减少(图12.1-6)。


图12.1-6 舍格伦综合征临床表现
唾液腺肿大以腮腺多见,多为双侧,肿大呈弥散性,边界不清,表面光滑,与周围组织无粘连;
大多数患者同时伴有类风湿性关节炎;类风湿因子阳性,抗核抗体阳性。
唾液腺造影显示主导管扩张,边缘不整齐,呈羽毛状或花边状。末梢唾液腺导管扩张呈点状、球状或腔状。
③病理改变
肉眼观:腺体弥漫性肿大或呈结节状包块,剖面呈灰白色。
镜下观: 病变从小叶中心开始。
最初:淋巴细胞浸润于腺泡间(图12.1-7)。

图12.1-7 舍格伦综合征(最初)
发展:腺泡破坏、消失,淋巴细胞可形成淋巴滤泡。导管上皮可增生扩张、形成囊腔(图12.1-8)。

图12.1-8 舍格伦综合征(发展)
最终:腺泡全部消失,为淋巴细胞、组织细胞替代,但小叶轮廓保留(图12.1-9)。

图12.1-9 舍格伦综合征(最终)
与唾液腺炎鉴别:小叶内无纤维组织修复(图12.1-10)。

图12.1-10 舍格伦综合征与慢性唾液腺炎
其中出现上皮肌上皮岛(图12.1-11),细胞多边形、泡状核,上皮内有嗜酸性无定型物。

图12.1-11 上皮肌上皮岛
小唾液腺尤其唇腺常同大唾液腺一样有同样的病变(但上皮肌上皮岛罕见),因此多取唇腺活检(图12.1-12)。

图12.1-12 唇腺活检
唇腺活检:以小叶内导管周围局灶性淋巴细胞浸润程度为评价标准,50个以上淋巴细胞局灶性浸润为1灶。存在1灶/4mm2以上的淋巴细胞浸润对诊断有意义。舍格伦综合征多表现为3度或4度。


